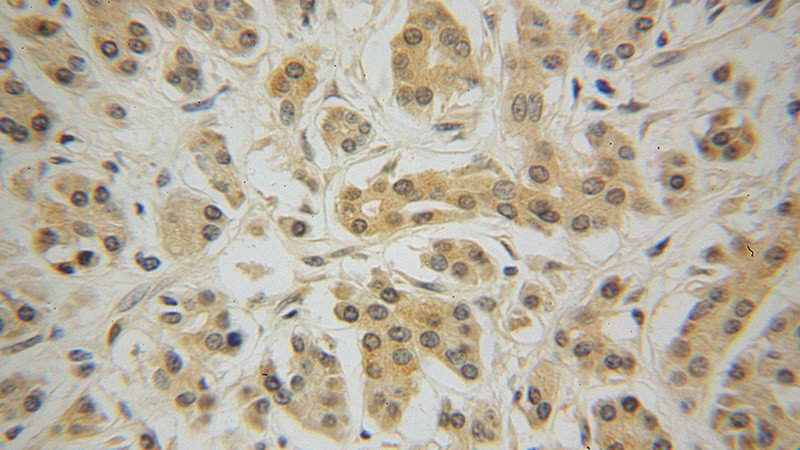
Immunohistochemical of paraffin-embedded human pancreas cancer using Catalog No:113492(SERPINE1 antibody) at dilution of 1:50 (under 40x lens)

-
Product Name
PAI-1 antibody
- Documents
-
Description
PAI-1 Rabbit Polyclonal antibody. Positive IHC detected in human pancreas cancer tissue. Positive IF detected in SH-SY5Y cells. Positive IP detected in SH-SY5Y cells. Positive WB detected in SH-SY5Y cells, human vein tissue. Observed molecular weight by Western-blot: 50-55 kDa and 110 kDa
-
Tested applications
ELISA, IHC, WB, IP, IF
-
Species reactivity
Human,Mouse,Rat; other species not tested.
-
Alternative names
PAI antibody; PAI 1 antibody; PAI1 antibody; PAI-1 antibody; PLANH1 antibody; Serpin E1 antibody; SERPINE1 antibody; PAI-1 antibody
-
Isotype
Rabbit IgG
-
Preparation
This antibody was obtained by immunization of PAI-1 recombinant protein (Accession Number: NM_000602). Purification method: Antigen affinity purified.
-
Clonality
Polyclonal
-
Formulation
PBS with 0.02% sodium azide and 50% glycerol pH 7.3.
-
Storage instructions
Store at -20℃. DO NOT ALIQUOT
-
Applications
Recommended Dilution:
WB: 1:200-1:2000
IP: 1:200-1:1000
IHC: 1:20-1:200
IF: 1:50-1:500
-
Validations

SH-SY5Y cells were subjected to SDS PAGE followed by western blot with Catalog No:113492(SERPINE1 antibody) at dilution of 1:500

Immunohistochemical of paraffin-embedded human pancreas cancer using Catalog No:113492(SERPINE1 antibody) at dilution of 1:50 (under 10x lens)
Immunohistochemical of paraffin-embedded human pancreas cancer using Catalog No:113492(SERPINE1 antibody) at dilution of 1:50 (under 40x lens)

IP Result of anti-SERPINE1 (IP:Catalog No:113492, 3ug; Detection:Catalog No:113492 1:300) with SH-SY5Y cells lysate 2000ug.

Immunofluorescent analysis of (-20oc Ethanol) fixed SH-SY5Y cells using Catalog No:113492(SERPINE1 Antibody) at dilution of 1:50 and Alexa Fluor 488-congugated AffiniPure Goat Anti-Rabbit IgG(H+L)
-
Background
SERPINE1, also named as Plasminogen activator inhibitor type 1 (PAI-1), is a member of the serine protease inhibitor (SERPIN) superfamily. PAI-1 is the principal inhibitor of tissue plasminogen activator (tPA) and urokinase (uPA), and hence is an inhibitor of fibrinolysis. Defects in this gene are the cause of plasminogen activator inhibitor-1 deficiency (PAI-1 deficiency), and high concentrations of the gene product are associated with thrombophilia. In western blotting, we got two bands 55 kDa and 110 kDa, and we are unsure as to the identity of the extra 110 kDa band.
-
References
- Zhi X, Xu C, Zhang H. Tryptase promotes atherosclerotic plaque haemorrhage in ApoE-/- mice. PloS one. 8(4):e60960. 2013.
- Li S, Li X, Wang Y, Yang J, Chen Z, Shan S. Global secretome characterization of A549 human alveolar epithelial carcinoma cells during Mycoplasma pneumoniae infection. BMC microbiology. 14:27. 2014.
- Liu Z, Gao Y, Hao F. Secretomes are a potential source of molecular targets for cancer therapies and indicate that APOE is a candidate biomarker for lung adenocarcinoma metastasis. Molecular biology reports. 41(11):7507-23. 2014.
- Yu GT, Bu LL, Zhao YY. Inhibition of mTOR reduce Stat3 and PAI related angiogenesis in salivary gland adenoid cystic carcinoma. American journal of cancer research. 4(6):764-75. 2014.
- Sun ZJ, Yu GT, Huang CF. Hypoxia induce TFE3 expression in head and neck squamous cell carcinoma. Oncotarget. 2016.
Related Products / Services
Please note: All products are "FOR RESEARCH USE ONLY AND ARE NOT INTENDED FOR DIAGNOSTIC OR THERAPEUTIC USE"
